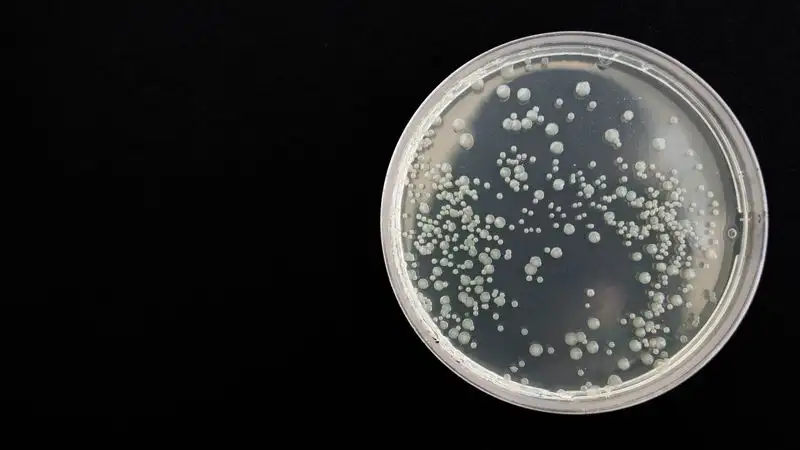

Гиният об отравлении детей в Караганде: Анализы на кишечные инфекции дают отрицательный результат
Фото: pixabay
Фото: pixabay
Глава министерства сообщила, что группа ведущих специалистов Минздрава вместе с местными врачами оказывает детям всю необходимую медпомощь.
По ее словам, изначально дети поступили с диагнозом "пищевое отравление под вопросом", так как жаловались на повышенную температуру, рвоту и боли в животе.
"На сегодняшний день шестеро находятся в тяжелом состоянии в реанимации, двое из них в крайне тяжелом состоянии. У остальных пяти на фоне проводимого лечения состояние удовлетворительное. Они еще будут находиться под наблюдением врачей. Если их состояние будет стабильным, завтра детей переведут обратно в центр", – сказала Ажар Гиният.
Она добавила, что сегодня при обходе врачей еще двое пожаловались на боли в животе. Их перевели в стационар и они находятся под наблюдением.
"Тяжесть заболевания детей обусловлена выраженной интоксикацией и дыхательной недостаточностью. Из-за чего у детей такое тяжелое состояние, на сегодняшний день врачи разбираются. Все анализы находятся на рассмотрении. Предварительно первые анализы на какие-то кишечные инфекции дают отрицательный результат".Ажар Гиният
Журналисты поинтересовались у главы Минздрава, рассматривается ли вариант химического отравления детей.
"Не исключаются все причины. Биологические материалы от детей, в том числе секционные материалы от умершего ребенка переданы на экспертизу", – заключила министр здравоохранения.
30 июля двое детей в Центре оказания специальных услуг для детей Карагандинской области почувствовали недомогание – у них была рвота и жидкий стул. Еще 10 детей этого учреждения на следующий день (31 июля) госпитализировали с аналогичными симптомами. Несмотря на все усилия врачей, спасти одного ребенка не удалось.
От работы отстранили исполняющую обязанности директора центра, а также 12 медиков.













